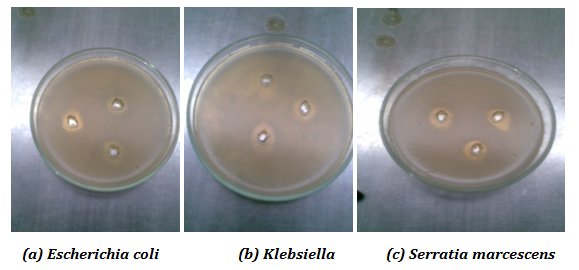

Int J Pharm Pharm Sci, Vol 7, Issue 1, 139-141Original Article
SYNTHESIS, CHARACTERIZATION AND ANTIBACTERIAL ACTIVITY OF NANO ZERO-VALENT IRON IMPREGNATED CASHEW NUT SHELL
D. PRABU1*, R. PARTHIBAN2, P. SENTHIL KUMAR3, S. KARTHICK RAJA NAMASIVAYAM4
1Department of Chemical Engineering, Sathyabama University, Chennai 603119, India, 2Department of Chemical Engineering, Sri Venkateswara College of Engineering, Chennai 602117, India, 3Department of Chemical Engineering, SSN College of Engineering, Chennai 603110, India, 4Department of Biotechnology, Sathyabama University, Chennai 603119, India.
Email: dprabhu78@gmail.com
Received: 17 Oct 2014 Revised and Accepted: 20 Nov 2014
ABSTRACT
Objective: The present study is focussed on the synthesis and evaluation of the antibacterial activity of nano zero-valent iron (NZVI) impregnated cashew nut shell (NZVI-CNS). Antibacterial activity was determined by adopting agar well diffusion method against selected bacteria.
Methods: The preparation was carried out by simple liquid-phase reduction method, namely, borohydride reduction method. The anti-bacterial activity of the NZVI-CNS was studied against by adopting well diffusion assay method. Superparamagnetism behaviour has been studied using a permanent bar ferro magnet.
Results: The nanoparticles obtained have been characterized with various techniques like Scanning Electron Microscopy (SEM) and Transmission Electron microscope (TEM) analyses. These techniques showed that the formations of NZVI with an average size of 50 to 100 nm and also it was found to be hexagonal and spherical in shape. The obtained NZVI impregnated CNS exhibits better superparamagnetism phenomenon. The synthesized cashew nut shell impregnated NZVI had the potential to inhibit the bacterial strains Escherichia coli, Klebsiella and Serratia marcescens.
Conclusion: The synthesis process for NZVI nanoparticles impregnated CNS is simple, cost-effective, and eco-friendly. The synthesized NZVI impregnated CNS had the greater potential as effective growth inhibitors in the various microorganisms and this can be applied to the diverse pharmacological applications.
Keywords: Cashew nut shell, Nano zero valent iron, Electron microscopy.
INTRODUCTION
Application of nano zero-valent iron (NZVI) in the water / wastewater treatment is a prominent technology, which was successfully used to treat the various metallic ions such as Cu2+, Cr2+, Pb2+, Ba2+ etc from the wastewater. Since, from ancient time’s antibacterial effect of silver and bactericidal effect of silver ions in catheters, burn wounds and dental work was known [1]. Various researchers have also been reported that the silver and copper ions were used as superior disinfectants for wastewater generated from hospitals containing infectious microorganisms [2, 3]. The residual copper and silver ions in the purified water adversely affect the human health [4]. The emergence of the nanoscience and nanotechnology in the last decade presents opportunities for exploring the bactericidal effect of metal nanoparticles. The bactericidal effect of metal nanoparticles has been attributed to their small size and high surface to volume ratio, which allows them to interact closely with microbial membranes and is not merely due to the release of metal ions in solution [5].
Nano zero-valent iron is particularly attractive for bioremediation purposes due to their significant surface area to weight ratio leading to a greater density of reactive sites and heavy metal removal capacity. Moreover, the magnetic properties of nano iron facilitate the rapid separation of nano iron from soil and water through a magnetic field. Advances in nanotechnology helps to synthesize the various types of metal and metal oxide nanoparticles with antimicrobial activities [6-10]. These compounds have a wide range of potential applications in biomedical fields, in textile fabrics [8], and in water treatment as disinfectants [9] or antibiofilm agents [10].
The antimicrobial properties of silver nanoparticles were well established [11-13] and several mechanisms for their bactericidal effects have been proposed. Although only a few studies have reported the antibacterial properties of NZVI which show the nano zero-valent iron nanoparticles have a significant promise as bactericidal agent. The nano zero-valent iron nanoparticles have been most intensively investigated due to their strong antimicrobial activity and the relatively low toxicity to humans [14, 15]. The present research is mainly involved in the preparation of inexpensive and effective bactericidal agents by impregnating the NZVI to the cashew nut shell (CNS). The CNS is an agricultural waste and which was used as a carrier for the NZVI. The NZVI particles were impregnated with the cashew nut shell by the simple liquid-phase reduction process and the obtained materials were checked for its bactericidal effect.
MATERIALS AND METHODS
Preparation of NZVI impregnated CNS (NZVI-CNS)
The preparation of NZVI-CNS was carried out by simple liquid-phase reduction process. About 1 g of CNS in powder form was first washed with water and then soaked in saturated FeSO4.7H2O solution (6.5g in 25 mL with 2 drops of concentrated H2SO4 solution) for half an hour. After that, the soaked CNS along with the saturated FeSO4.7H2O solution was sonicated in an ultrasonic bath (Sonics Vibra Cell 750 watt) for another half an hour. During sonication, the CNS particle gets broken down to small pieces. After sonication, 0.1 mol/L NaBH4 was added slowly at ambient temperature, pressure and atmosphere. The ferrous ion impregnated into the CNS was reduced to NZVI as per the following reaction:
Fe2+ +2BH4-Fe0 +2B3++ H2
When the evolution of hydrogen gas ceased, the water was decanted and the NZVI- CNS was collected. It was dried and stored in a container without any preservative or controlled atmosphere.
Antibacterial activity
The anti-bacterial activity of Nanozero valent iron nanoparticles was studied against (adopting well diffusion assay). The strains such as E. coli, Klebsiella and Serratia marcescens were obtained from Madurai Medical College Hospital, Tamilnadu, India and these were maintained on Tryptic soy agar (TSA) slants. A loopful of slant culture was inoculated into tryptic soy broth and incubated at 37 ºC for about 12-16 hours to reach the mild log phase. The bacteria were harvested by centrifugation at 1000 × g for 10 min and this washed twice with 50 mL of 150 mM phosphate buffered saline (PBS, pH 7.2). The stock suspension of strains was prepared by re-suspending the final pellets in 50 mL of 150 mM PBS solutions. The respective broth culture was uniformly spread with sterile cotton swabs on sterile Mueller Hinton (MH) Agar Media (Hi-media, India). The wells were made using cork borer and aliquots of nano zero-valent iron particles (aliquots of 25, 50, 75 µg/ml were prepared from concentrated nanoparticles) was loaded into the wells. The plates were incubated at 37 °C for about 24 hours.
Characterization
Transmission Electron Microscopic (TEM) analysis were carried out by drop coating NZVI-CNS onto carbon-coated TEM grids using a Philips Technai-10. TEM grids were allowed to dry and the extra solution was removed by using a blotting paper. The surface morphology of the NZVI-CNS was studied by Scanning Electron Microscopic (SEM) analysis and this was performed on a XL30 FE-SEM. Super paramagnetic behaviour was studied by using a permanent ferro magnet.
RESULTS AND DISCUSSION
TEM image of NZVI-CNS synthesized using the sodium borohydride method. The size and shape of the NZVI-CNS particles was determined by TEM analysis. A drop of aqueous N NZVI-CNS sample was loaded on carbon-coated copper TEM grid. It was allowing water to evaporate and dry completely for an hour at room temperature. The TEM micrograph image were recorded on a JEOL 1200 EX instrument on carbon coated copper grids with an accelerating voltage of 100 to 200 kV. The clear microscopic views were observed and documented in different ranges of magnifications. The nanoparticles were mostly spherical, triangular in shape and exist as chain-like aggregates. An accumulative size distribution survey of over 400 nanoparticles from TEM images suggests that over 80% of the nanoparticles had diameters of less than 100 nm whereas 50% were less than 60 nm (Fig. 1).

Fig. 1: TEM image of NZVI-CNS
Scanning Electron Microscopic (SEM) image of NZVI-CNS particle was shown in Fig. 2. SEM micrographs shows aggregates of NZVI and the spherical particles are in the range of 100 nm and they are not in the direct contact even within the aggregates indicating the stabilization of nanoparticles by cashew nut shell (Fig 2). NZVI-CNS particles are particularly attractive towards permanent Ferro bar magnet which exhibit super paramagnetism (Fig 3). The magnetic properties facilitate the rapid separation of the nanoparticles from soil and water through a magnetic field.

Fig. 2: SEM images of synthesized NZVI-CNS

Fig. 3: Superparamagnetic behaviour
Fig. 4: Zone of inhibition (mm) for (a) E. coli, (b) Klebsiella, (c) Serratia marcescens
Table 1: Zone of inhibition for tested bacteria
S. No. |
Tested bacteria |
Zone of inhibition (mm) ** |
||
25 µg/mL |
50 µg/mL |
75 µg/mL |
||
1. |
E. Coli |
10.4 |
11.0 |
12.0 |
2. |
Klebsiella |
9.0 |
10.5 |
13.5 |
3. |
Serratia marcescens |
9.3 |
10.2 |
13.7 |
** Each value in the table was obtained by calculating the mean value of three experiments
Anti bacterial activity reveals that the tested strains were found to be susceptible to the nanoparticles treatment.10.4, 11.0, 12.0 mm and 9.0, 10.0, 13.0 mm of zone of inhibition (Fig 4) were recorded in E. coli, Klebsiella sp (Table 1). The similar finding was also recorded in Serratia marcesens. Antibacterial activity of biogenic NZVI synthesized from a green tea extract against pathogenic bacteria has been reported [15]. Further study may be helpful in formulating the NZVI for the diverse pharmacological applications.
CONCLUSION
In summary, the synthesis and characterization of the NZVI-CNS were studied by TEM and SEM analyses. The superparamagneic behaviour was studied by a permanent ferro bar magnet. Antibacterial activity of nanopartilces was investigated against selected strains such as E. coli, Klebsiella and Serratia marcesens. The results suggested that the NZVI-CNS particles can be used as effective growth inhibitors in various microorganisms, rendering them applicable to diverse medical devices and antimicrobial control systems.
CONFLICT OF INTEREST
The authors have declared that there is no conflict of interests.
ACKNOWLEDGEMENT
Authors are grateful to the Sathyabama University for the research facilities provided.
REFERENCES
- Kim JS, Kuk E, Yu KN, Kim JH, Park SJ, Lee HJ, et al. Antimicrobial effects of silver nanoparticles. Nano Med 2007;3:95–101.
- Lin YE, Vidic RD, Stout JE, Yu VL. Individual and combined effects of copper and silver ions on inactivation of Legionella pneumophila. Water Res 1996;30:1905–13.
- Lin YE, Vidic RD, Stout JE, McCartney CA, Yu VL. Inactivation of Mycobacterium avium by copper and silver ions. Water Res 1998;32:1997–2000.
- Blanc DS, Carrara P, Zanetti G, Francioli P. Water disinfection with ozone, copper and silver ions, and temperature increase to control Legionella: seven years of experience in a university teaching hospital. J Hosp Infect 2005;60:69–72.
- Morones JR, Elechiguerra JL, Camacho A, Holt K, Kouri JB, Ramirez JT, et al. The bactericidal effect of silver nanoparticles. Nanotechnol 2005;16:2346–56.
- Alt V, Bechert T, Steinrcke P, Wagener M, Seidel P, Dingeldein E, et al. An in vitro assessment of the antibacterial properties and cytotoxicity of nanoparticulate silver bone cement. Biomaterials 2004;25:4383–91.
- Furno F, Morley KS, Wong B, Sharp BL, Arnold PL, Howdle SM, et al. Silver nanoparticles and polymeric medical devices: a new approach to prevention of infection. J Antimicrob Chemother 2004;54:1019–24.
- Jeong SH, Yeo SY, Yi SC. The effect of filler particle size on the antibacterial properties of compounded polymer/silver fibers. J Mater Sci 2005;40:5407–11.
- Chou WL, Yu DG, Yang MC. The preparation and characterization of silver-loading cellulose acetate hollow fiber membrane for water treatment. Polym Adv Technol 2005;16:600–7.
- Sambhy V, MacBride MM, Peterson BR, Sen A. Silver bromide nanoparticle/polymer composites: dual action tunable antimicrobial materials. J Am Chem Soc 2006;128:9798–808.
- Sondi I, Salopek-Sondi B. Silver nanoparticles as antimicrobial agent: a case study on E. coli as a model for gram-negative bacteria. J Colloid Interf Sci 2004;275:177–82.
- Siva Kumar V, Nagaraja BM, Shashikala V, Padmasri AH, Madhavendra SS, Raju BD, et al. Highly efficient Ag/C catalyst prepared by electro-chemical deposition method in controlling microorganisms in water. J Mol Catal A Chem 2004;223:313–9.
- Jain P, Pradeep T. Potential of silver nanoparticle-coated polyurethane foam as an antibacterial water filter. Biotechnol Bioeng 2005;90:59–63.
- Lee C, Kim KY, Lee W, Nelson KL, Yoon J, Sedlak L. Bactericidal effect of zero-valent iron nanoparticles on Escherichia coli. Environ Sci Technol 2008;42(13):4927–33.
- George robin AT, Karthick Raja Namasivayam S, Sathyanarayana Raju. Synthesis, Characterization and anti-bacterial activity of chitosan stabilized nano zero valent iron. Bull Pharm Med Sci (BOPAMS) 2013;1(1):7-11.